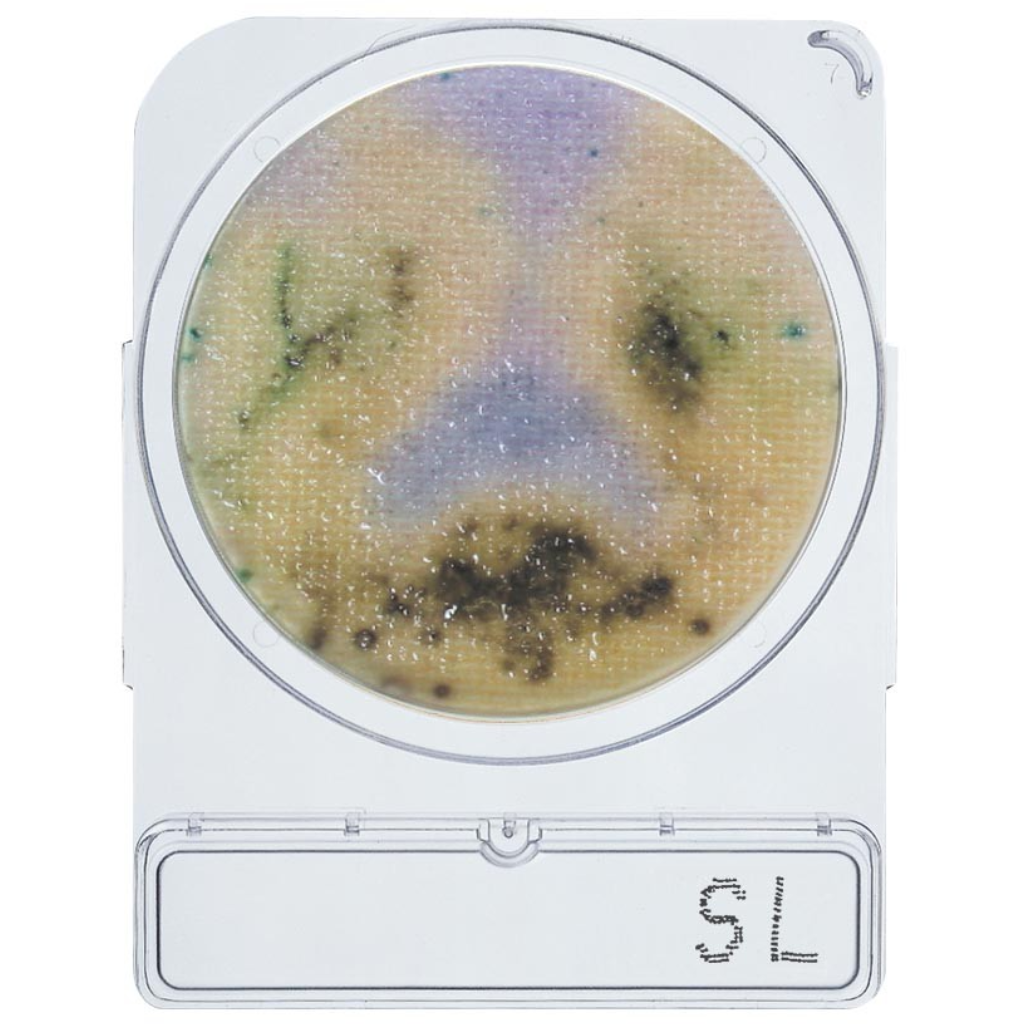
Compact Dry SL

Compact Dry SL
- Ready and easy to use portable plate: Preparation of medium is not required, which eliminates waste of medium as well as sterilizing apparatus to prepare the medium.
- Detection of colonies on plate is simple and clear.
- Single colonies on the plate can be isolated for further identification tests
Ready-to-use petri dishes for reliable microbiological analysis for Salmonella spp.
Compact Dry SL detects salmonella using 20 - 24 hour pre-enrichment cultures. The plates are based on the combination of three different test principles:
1. Alkalization of the medium, by Salmonella´s lysine decarboxylase ability (the medium colour will change from blue-purple to yellow)
2. Greening of the colony, caused by decomposition of chromogenic substrate with a specific enzyme of Salmonella (black colonies are generated by hydrogen sulphide producing Salmonella)
3. The motility of Salmonella
Additionally, the colonies isolated from Compact Dry SL can be used for confirmation of Salmonella. Coliforms generate color change from blue-purple to red-purple by fermented lactose and/or sucrose in the medium. Please follow this operating procedure precisely, especially how to inoculate sample and sterilized water, to exploit the specific advantages of Compact Dry SL.
Incubation time and temperature: 37 ± 1 °C for 18 ± 2 hours and 41.5 ± 1 °C for 24 ± 3 hours
Shelf life: 12 months after manufacturing.
Storage: Room temperature (1 - 30 °C)
Preparation of Apparatus and Materials
1) Prepared and sterilized medium made from Buffered Peptone Water (BPW) or EEM Broth Hyserve Ident No. 1000071
2) Sterilized homogenize bag with filter
3) Homogenizer
4) Stand for homogenize bag
5) Sterilized disposable pipette (1mL) or sterilized measuring pipette
6) Sterilized water
7) Incubator (36±1°C and 42±1°C)
Preparation of Specimen
1) Solid Foodstuffs:
Take 25g of solid specimen into the sterilized homogenizer bag. Add 225 mL of sterile Buffered Peptone Water or EEM Broth into the bag, and homogenize with stomacher for about one (1) minute.
2) Water or Liquid Foodstuffs:
Add 9 times volume of Buffered Peptone Water or EEM Broth to liquid specimen. Filtrate the liquid sample through membrane filter, and put the filter into BPW or EEM Broth.
3) Wiped sample:
Add 9 times volume of Buffered Peptone Water or EEM Broth to the whole liquid made from wiped samples.
Direction
1) Prepared specimen shall be kept in the closed homogenized bag, and incubate the bag 20 - 24 hours at 35 – 37 °C in the incubator for pre-enrichment.
2) Take the bag out from the incubator and rub the bag for homogenization. Use sterilized disposable pipette for sample inoculation. Drop 0.1 mL (3 drops from the 1 mL pipette) of enriched specimen on the dry sheet (approx. 1 cm far from the edge of plate) gently. This enriched culture will stay at dropped point. Diffusion of this dropped specimen shall not
reach to the edge of plate.
3) After the inoculation of the enriched culture, drop 1mL of sterilized water gently at the opposite point where the specimen dropped. Sterilized water will diffuse automatically and the sheet will be wet uniformly.
4) Turn over the plate capped, put in an incubator and incubate 20 - 24 hours at 41 – 43 °C.